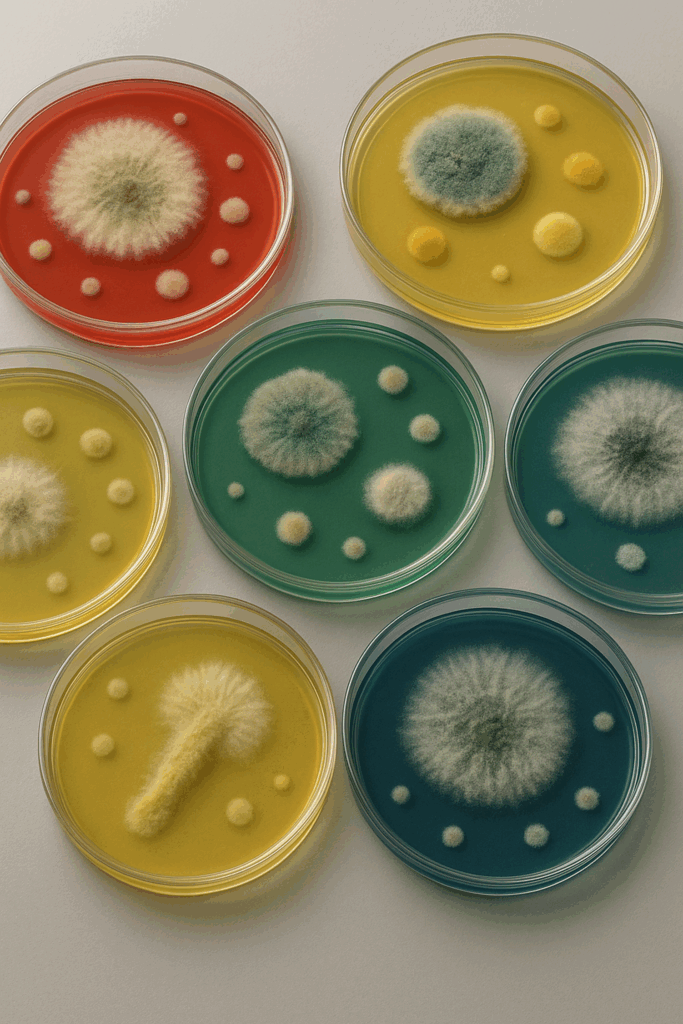

? E’ partito a maggio 2023 il progetto #??????????????: ?????????? ?-?? vincitore del bando regionale DGR 2241/2022 per coinvolgere le fasce di popolazione più fragili e a rischio di esclusione sociale provenienti da tutto l’ambito distrettuale della pianura ovest.
? Il ?????? ???????????? ??????? ??????????-??? ha presentato un progetto in sinergia con un’ampia rete di Associazioni e realtà locali quali il Centro Famiglia (con Emporio e Oltre la scuola), il Centro Sociale “La Stalla”, il Gruppo Astrofili PERSicetani, la Cooperativa Fanin (con Centro diurno e Atelier), l’IIS Archimede (gruppo diversamente abili), Passo Passo/sez. Crevalcore per svolgere incontri volti ad accogliere e valorizzare l’unicità e la diversità di ogni persona come occasione di crescita personale e di confronto.
? ?? ?????? ???? ? ??????? ???? verranno svolte dai volontari della rete numerose attività ludiche con bambini, ragazzi, adulti e anziani oltre a laboratori di archeologia, astronomia, fisica ed entomologia presso le diverse strutture Museali del territorio grazie alla collaborazione con Agen.ter.
❤️ Le attività sono finanziate con Fondi del Ministero del lavoro e delle politiche sociali.
? Per ulteriori info sul bando: https://sociale.regione.emilia-romagna.it/bandi/2022/bando-sostegno-progetti-rilevanza-locale-2022-2024
Stay tuned!